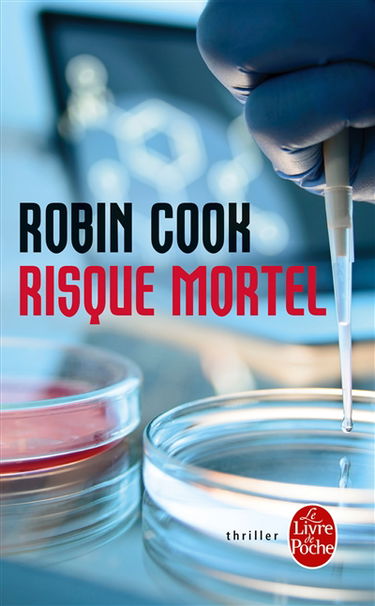
Risque mortel

Thrillers d’occasion
Découvrez tous nos livres d'occasion en ligne dans la catégorie thrillers. Remplissez votre panier et vos étagères avec de nouvelles lectures passionnantes : faites votre commande parmi des centaines de titres en thrillers à petit prix sur RecycLivre, avec livraison partout dans le monde ! Des livres de la catégorie thrillers à donner ? Retrouvez toutes nos solutions de collecte sur cette page. Vous préférez vous faire un peu d'argent et vendre vos livres de seconde main ? Rendez-vous sur notre application de rachat de livres, RecycLivre Rachète ! Lire la suite En voir moins
Affiner la sélection : Suspense, Thrillers d'espionnage, Crime et enquête, Thrillers judiciaires, Thrillers médico-scientifiques, Thrillers financiers